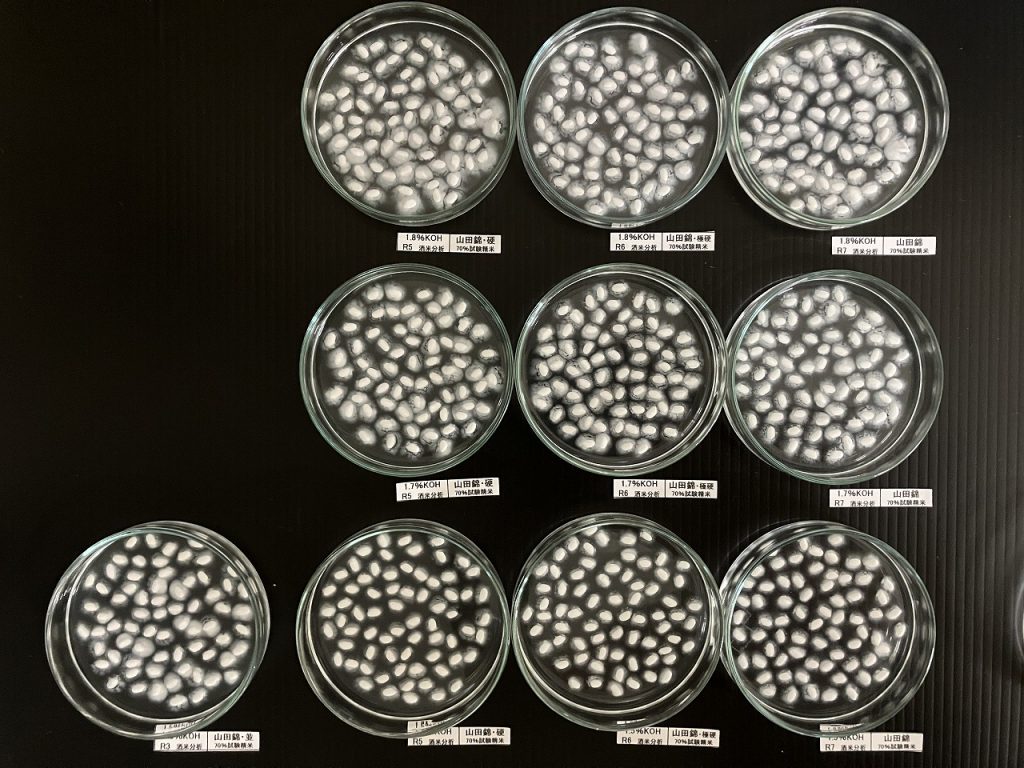

11/17
【今年の新米はどんな顔? 仕込み前の分析作業】
10月下旬になると、蔵には続々と新米が入荷してきます。
11月中旬からの使用に向けて、精米所では本格的に精米作業が進められていきます。
入荷した新米は、さまざまな分析を行いますが、酒造現場で特に気になるのは「溶解性」と「醗酵の強さ」です。
同じ産地・同じ品種のお米でも、その年の天候などの影響で毎年傾向が変わります。
そこで菊姫では、新米を仕込みに使う前にこの2点を事前に分析し、今年の醪の傾向を予測してから仕込みに臨むようにしています。


まずは「溶解性」の分析です。
試験精米機でお米を70%まで精米し、その試料を使って「アルカリ崩壊法」による分析を行います。
近年は気象条件の影響もあって溶けにくい、酒造現場では「硬い」と表現されるお米の年が多くなってきました。
ただ、一口に「硬い」といっても、実際の醪では濃度の出方などに違いが出てきます。
そのため、数値としてどの程度の「硬さ」なのかを、詳しく確認していきます。


一方、醪での「醗酵の強さ」は、カリウムというミネラルの含量を測定することで予想します。
この分析には、アルカリ崩壊用に試験精米したお米だけでなく、実際に使用する白米も用います。
実際の白米をサンプリングするときには、各ロットの平均的な状態をきちんと反映できるように採り方を工夫し、よく混ぜて均一な試料に整えます。



さらに、新米だけでなく、古米ロットや昨年度のお米も併せて分析します。
醪の経過への影響をより立体的にイメージできるよう、複数年度のデータをそろえてカリウム含量を比較し、今年のお米の特徴を掴んでいきます。
こうした事前の分析を通して、新米を使う前から今年度の傾向をかなり詳しく予測できるようになります。
いよいよ、今年の新米を使った仕込みが始まります。どのような味わいのお酒に育っていくのか、とても楽しみです。
